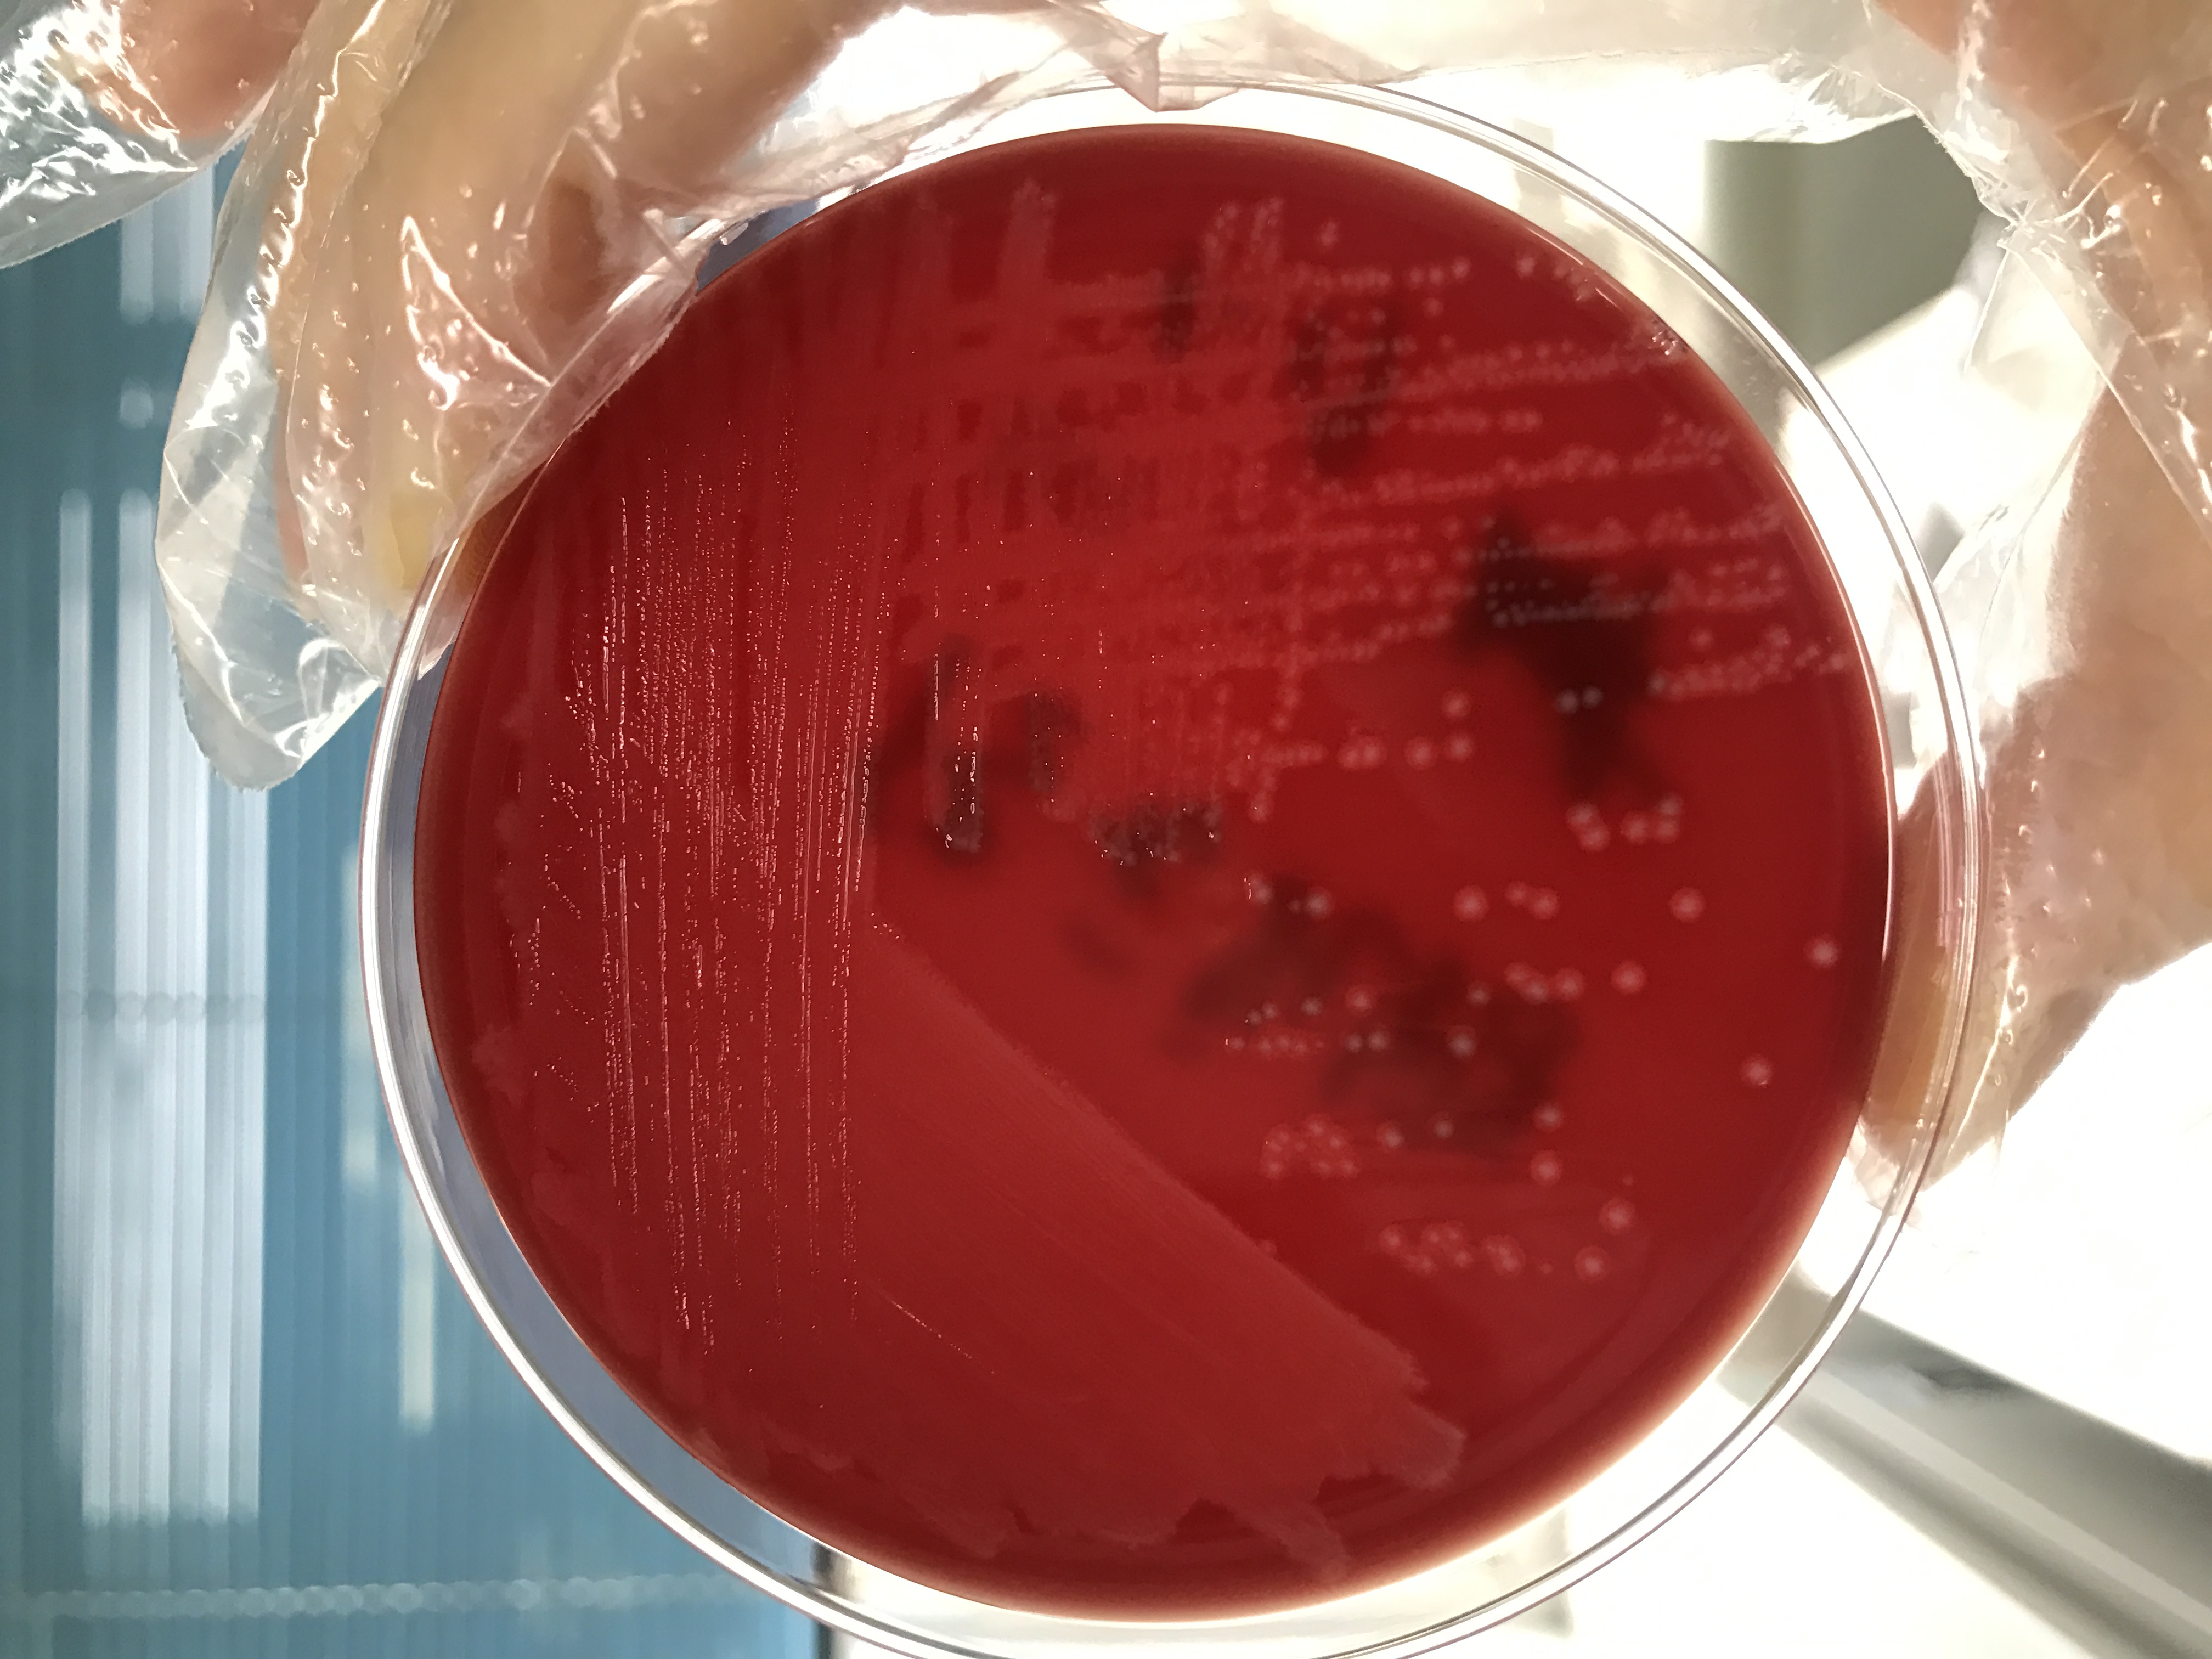
代孕对婴儿的健康危害,代孕婴儿的九大危害
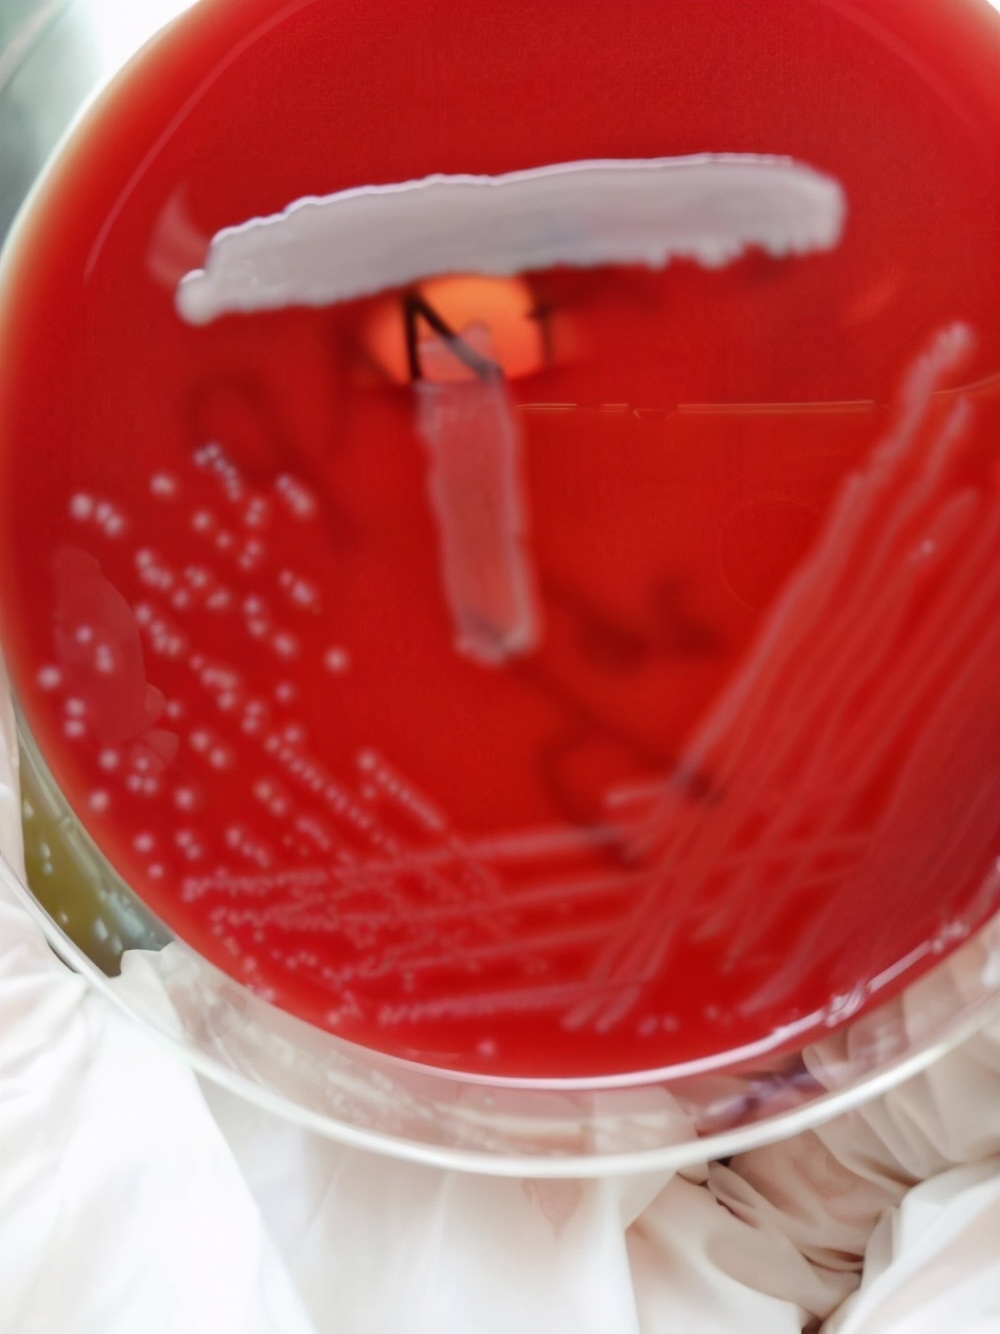
代孕对婴儿的健康危害,代孕婴儿的九大危害

一对明星夫妻的八卦新闻直接将“代孕”送上热搜
“人工生殖”本是为解决不孕不育而出现的幸事,圆了无数家庭的孩子梦。然而衍生出的“代孕”又遗弃孕育的孩子,已经超出了科学技术范畴,是对生命和伦理的违背。
“代孕”在国内是明令禁止的
生命的选择和进化,是大自然的结果,我们应该敬畏每一个生命,不能够去逾越生命的底线,人类科技发展至今,无论是人工受精,还是预防新生儿感染,都是源于对新生命的渴望和珍惜,对新生命的保护和尊重。我们医疗研究人员不断地更新研究结论,就是希望将每一个新生命很好的保护,从诞生到降生的每一个环节,每一个时刻都至关重要。
下面,从微生物的角度,来谈谈新生儿感染的预防
B族链球菌(group B streptococcus,GBS),又名无乳链球菌,它为一种正常定植于妇女生殖道及消化道下端的革兰阳性球菌,是引起新生儿侵袭性感染的主要原因,母婴传播是其感染的主要途径,尤其是经产道分娩时新生儿吞进和吸入GBS菌,可导致严重的肺炎、败血症及脑炎,造成新生儿死亡或神经系统后遗症。GBS20世纪90年代以来,美国与包括欧洲国家在内的其他西方发达国家通过实施和改进基于产前GBS筛查与产时抗生素干预(intrapartum antibioticprophylaxis,IAP)的预防策略,有效降低了新生儿早发型感染(0~6 d龄)
美国CDC推荐增菌后培养法为GBS培养筛查的"金标准",推荐妊晚期35~37孕周进行GBS常规培养筛查,那么无乳链球菌长什么样子呢?

无乳链球菌,透明溶血,革兰阳性球菌
无乳链球菌和金黄色葡萄球菌共同培养,可出现CAMP阳性现象,可以初步诊断,那结果是什么样子呢?
B族链球菌能产生一种物质(CAMP因子)使葡萄球菌β溶血素产生的溶血带增大
如培养发现无乳链球菌,则分娩时进行抗生素干预,进行预防新生儿感染。某医院回顾性分析了146例B族链球菌感染新生儿的资料,患儿1年预后,有102例生存,44例死亡,其中感染脑膜炎者有65例,可见GBS感染的风险确实存在,所以有效的预防措施还是应该积极采纳,分娩时筛查,若检出应该积极干预。我们首选的干预方式,就是青霉素静脉滴注。
还有一种情况,需要我们特别关注,青霉素过敏患者GBS感染应该怎么办呢?
这个时候,对于孕妇,我们不能盲目更换药物,需要我们检验人员,对其进行药敏实验,美国临床实验室标准化协会建议用纸片扩散试验或微量肉汤稀释试验进行GBS药敏试验。并建议对红霉素耐药、克林霉素敏感的GBS菌株,进行克林霉素诱导耐药检测(D试验)。如果D试验阳性,提示克林霉素诱导耐药,该菌株为克林霉素耐药。不建议应用,D试验阳性,什么样子呢?

邻近红霉素纸片侧克林霉素出现似字母D的抑菌环提示存在可诱导的克林霉素耐药
对于新生儿GBS感染预防最理想的是母体的疫苗接种,但由于尚处研发阶段,IAP仍为当前唯一有效的预防措施。所以建议围产期妇女,筛查阴道和直肠的无乳链球菌是有必要的,去保护好妈妈肚子里的小生命。